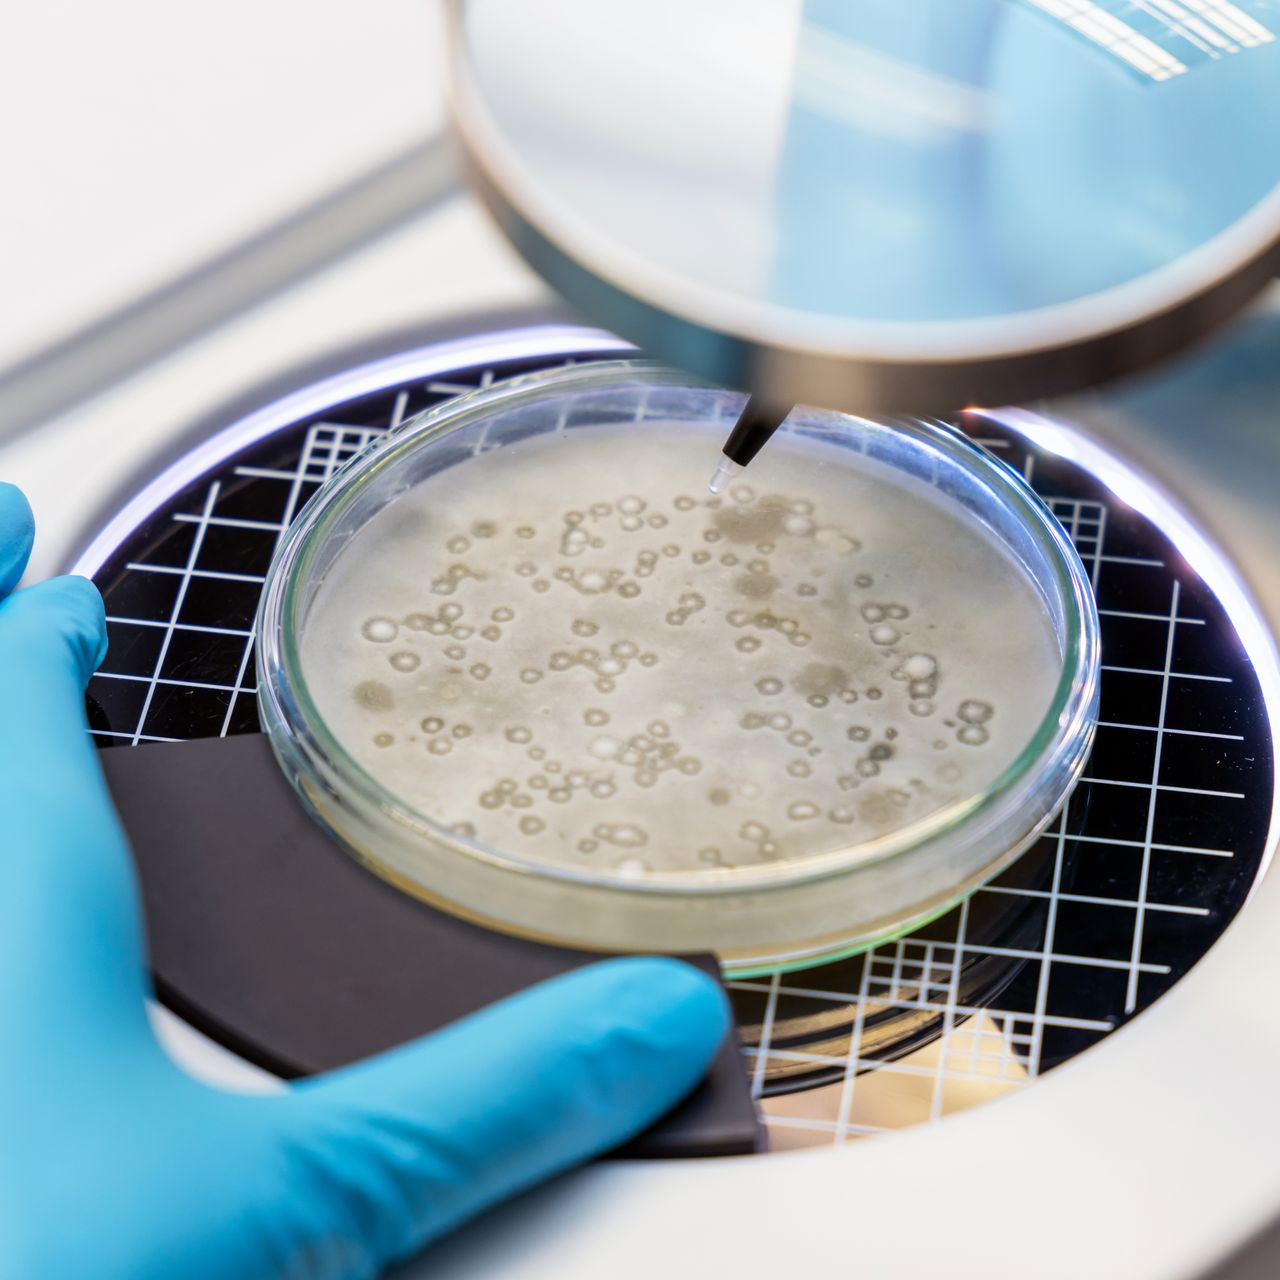
Mold Testing in Lab

Mold Inspection and Testing
Independent Third Party Mold Testing
If you're concerned about mold negatively impacting your indoor air quality, consider a mold inspection from SCCS NWI. We offer professional mold inspections and testing to homes and businesses in Northwestern Indiana and Southwestern Michigan. You can always trust the technicians at our family-owned business to get the job done right.
Whether you're purchasing a house, can see mold growth, are concerned about your children's health or have noticed a moldy smell, we can determine if you have a mold problem. For any of our mold services, call us at (219) 779-8198.
Our mold inspection process includes:
- A full visual inspection of the entire property
- Identification of red flag areas (excess moisture, water intrusion, visible mold growth)
- Air samples to determine whether elevated mold levels exist
- Additional air or surface sampling (optional)
- Lab results from an AIHA-accredited laboratory
- Detailed report with protocol for mold remediation (if necessary)
Get a quote
Our Mold Testing Approach
Our mold testing is designed to provide a clear, reliable picture of indoor conditions. Every test includes air and or surface sampling along with advanced analysis that looks beyond visible mold.
- Indoor air samples are compared to an outdoor baseline to determine whether mold levels inside the property are normal or elevated. Testing also identifies other particles commonly found in indoor air, which can help explain air quality concerns even when visible mold is not present.
- Results are delivered in an easy-to-understand report with clear determinations so you know whether conditions are normal or indicate a problem.
- Indoor air samples are compared to an outdoor control
- Surface testing is used when visible growth is present or suspected
- Mold and other common indoor particles are identified
- Reports provide clear determinations rather than raw data
- Samples ship same day with results typically available the next business day
Why should have professional mold inspection done on your home or business?
- Health complications
- Litigation
- Peace of mind
- Post-mold remediation clearance
- Real estate transaction
- Recent water damage
- Strange smells
- Visible growth

PROFESSIONAL MOLD REMEDIATION NEAR YOU
Our goal at SCCS NWI is to provide our residential and commercial clients with the best in mold testing, removal and mitigation services. Since 2012, we have helped many business owners and families throughout Northwest Indiana. No job is too big or too small! Call our locally owned business 24 hours a day, 7 days a week at (219) 779-8198.